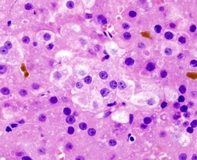

Yeni yayımlanan bir çalışmaya göre, ameliyat edilemeyen ilerlemiş karaciğer kanserinin doksorubisin artı sorafenib ile tedavisi, doksorubisin monoterapisi ile tedavi edilen hastalara kıyasla, genel sağkalımı ve progresyonsuz sağkalımı iyileştiriyor.
Hepatoselüler karsinomu (HCC), dünyada en sık görülen 6. malignite olup, her yıl yaklaşık 600 bin hastayı etkilemektedir. Ameliyat edilemeyen veya metastatik hastalığı olan kişilerin medyan sağkalımı yalnızca birkaç aydır. Kanıtlanmış bir sağkalım yararı olmamasına karşın, doksorubisin, HCC tedavisinde rutin olarak kullanılmaktadır. Sorafenibin de plaseboya kıyasla medyan sağkalımı istatistiksel olarak anlamlı düzeyde iyileştirdiği ortaya konmuştur. Yapılan faz I çalışmada, solid tümörlü hastalarda sorafenibin doksorubisin ile birlikte etkinliği ve tolere edilebilirliği değerlendirildi ve ümit verici sonuçlar elde edildi. Bununla birlikte, ilerlemiş HCC hastalarında sorafenib ve doksorubisin tedavisinin etkinliği faz II veya III çalışmalarda değerlendirilmedi.
New York, Memorial Sloan-Kettering Kanser Merkezi araştırmacılarından Dr. Ghassan K. Abou ve ekibi, ilerlemiş HCC hastalarında doksorubisin artı sorafenib ile doksorubisin artı plasebonun etkinliğini karşılaştıran, randomize, faz II bir çalışma yürüttü. Nisan 2005’den Ekim 2006’ya kadar yürütülen çalışmaya 96 hasta (%76 erkek; medyan yaş 65) dahil edildi. Hastalar, her 21 günde bir intravenöz doksorubisine ve günde iki kere oral sorafenib veya plaseboya randomize edildi. Son hasta takip tarihi, Nisan 2008’di.
Çalışma tamamlandıktan sonra, bağımsız bir veri takip kurulu etkinliğin planlanmamış erken analizini yaptı. Böylece çalışma durdurulmuş oldu. Plasebo kolunda kalan son iki hastaya da sorafenib verildi. Hastalık progresyonuna kadar geçen sürede toplam 51 olay (doksorubisin artı sorafenib grubunda 24; doksorubisin artı plasebo grubunda 27) kaydedildi. Hastalık progresyonuna kadar geçen medyan süre, doksorubisin artı sorafenib verilen hastalarda 6.4 ayken, doksorubisin artı plasebo grubunda 2.8 aydı.
Çalışma süresince 63 hasta öldü (doksorubisin artı sorafenib grubunda 25; doksorubisin artı plasebo grubunda 38 hasta). Medyan genel sağkalım doksorubisin artı sorafenib grubunda 13.7 ay, doksorubisin artı plasebo grubunda 6.5 aydı. Plaseboya kıyasla doksorubisin artı sorafenib ile tedavi edilen hastalarda ölüm riski %51 oranında azaldı.
Total progresyonsuz sağkalım sayısı 70’ti (doksorubisin artı sorafenib grubunda 32; doksorubisin artı plasebo grubunda 38). Doksorubisin artı sorafenib ile tedavi edilen hastalarda medyan progresyonsuz sağkalım 6 ayken, doksorubisin artı plasebo grubunda 2.7 aydı. Plaseboya kıyasla doksorubisin artı sorafenib ile tedavi edilen hastalarda progresyon veya ölüm riski %46 oranında azaldı.
İlaçların toksisite profilleri de birbiriyle benzerlik gösterdi. Özet olarak, ilerlemiş HCC tedavisi alan hastalarda doksorubisin artı sorafenib, doksorubisin artı plasebo ile karşılaştırıldı ve çalışma sonunda progresyona kadar geçen sürede, genel sağkalımda ve progresyonsuz sağkalımda iyileşmeler kaydedildi. Sorafenib ve doksorubisin arasındaki sinerjinin ne derece iyileşme sağlayacağı kesin olarak bilinmemekle birlikte, araştırmacılar bu çalışmanın, sorafenib artı plasebo ile sorafenib artı doksorubisinin kıyaslandığı, devam eden faz III çalışma için temel oluşturduğunu ifade etti.
KAYNAK: Ghassan K. Abou-Alfa; Philip Johnson; Jennifer J. Knox; Marinela Capanu; Irina Davidenko; Juan Lacava; Thomas Leung; Bolorsukh Gansukh; Leonard B. Saltz. Doxorubicin Plus Sorafenib vs Doxorubicin Alone in Patients With Advanced Hepatocellular Carcinoma: A Randomized Trial. 2010; 304 (19): 2154-2160 DOI: 10.1001/jama.2010.1672
YAZIYI PAYLAŞ
YORUMUNUZ VAR MI?